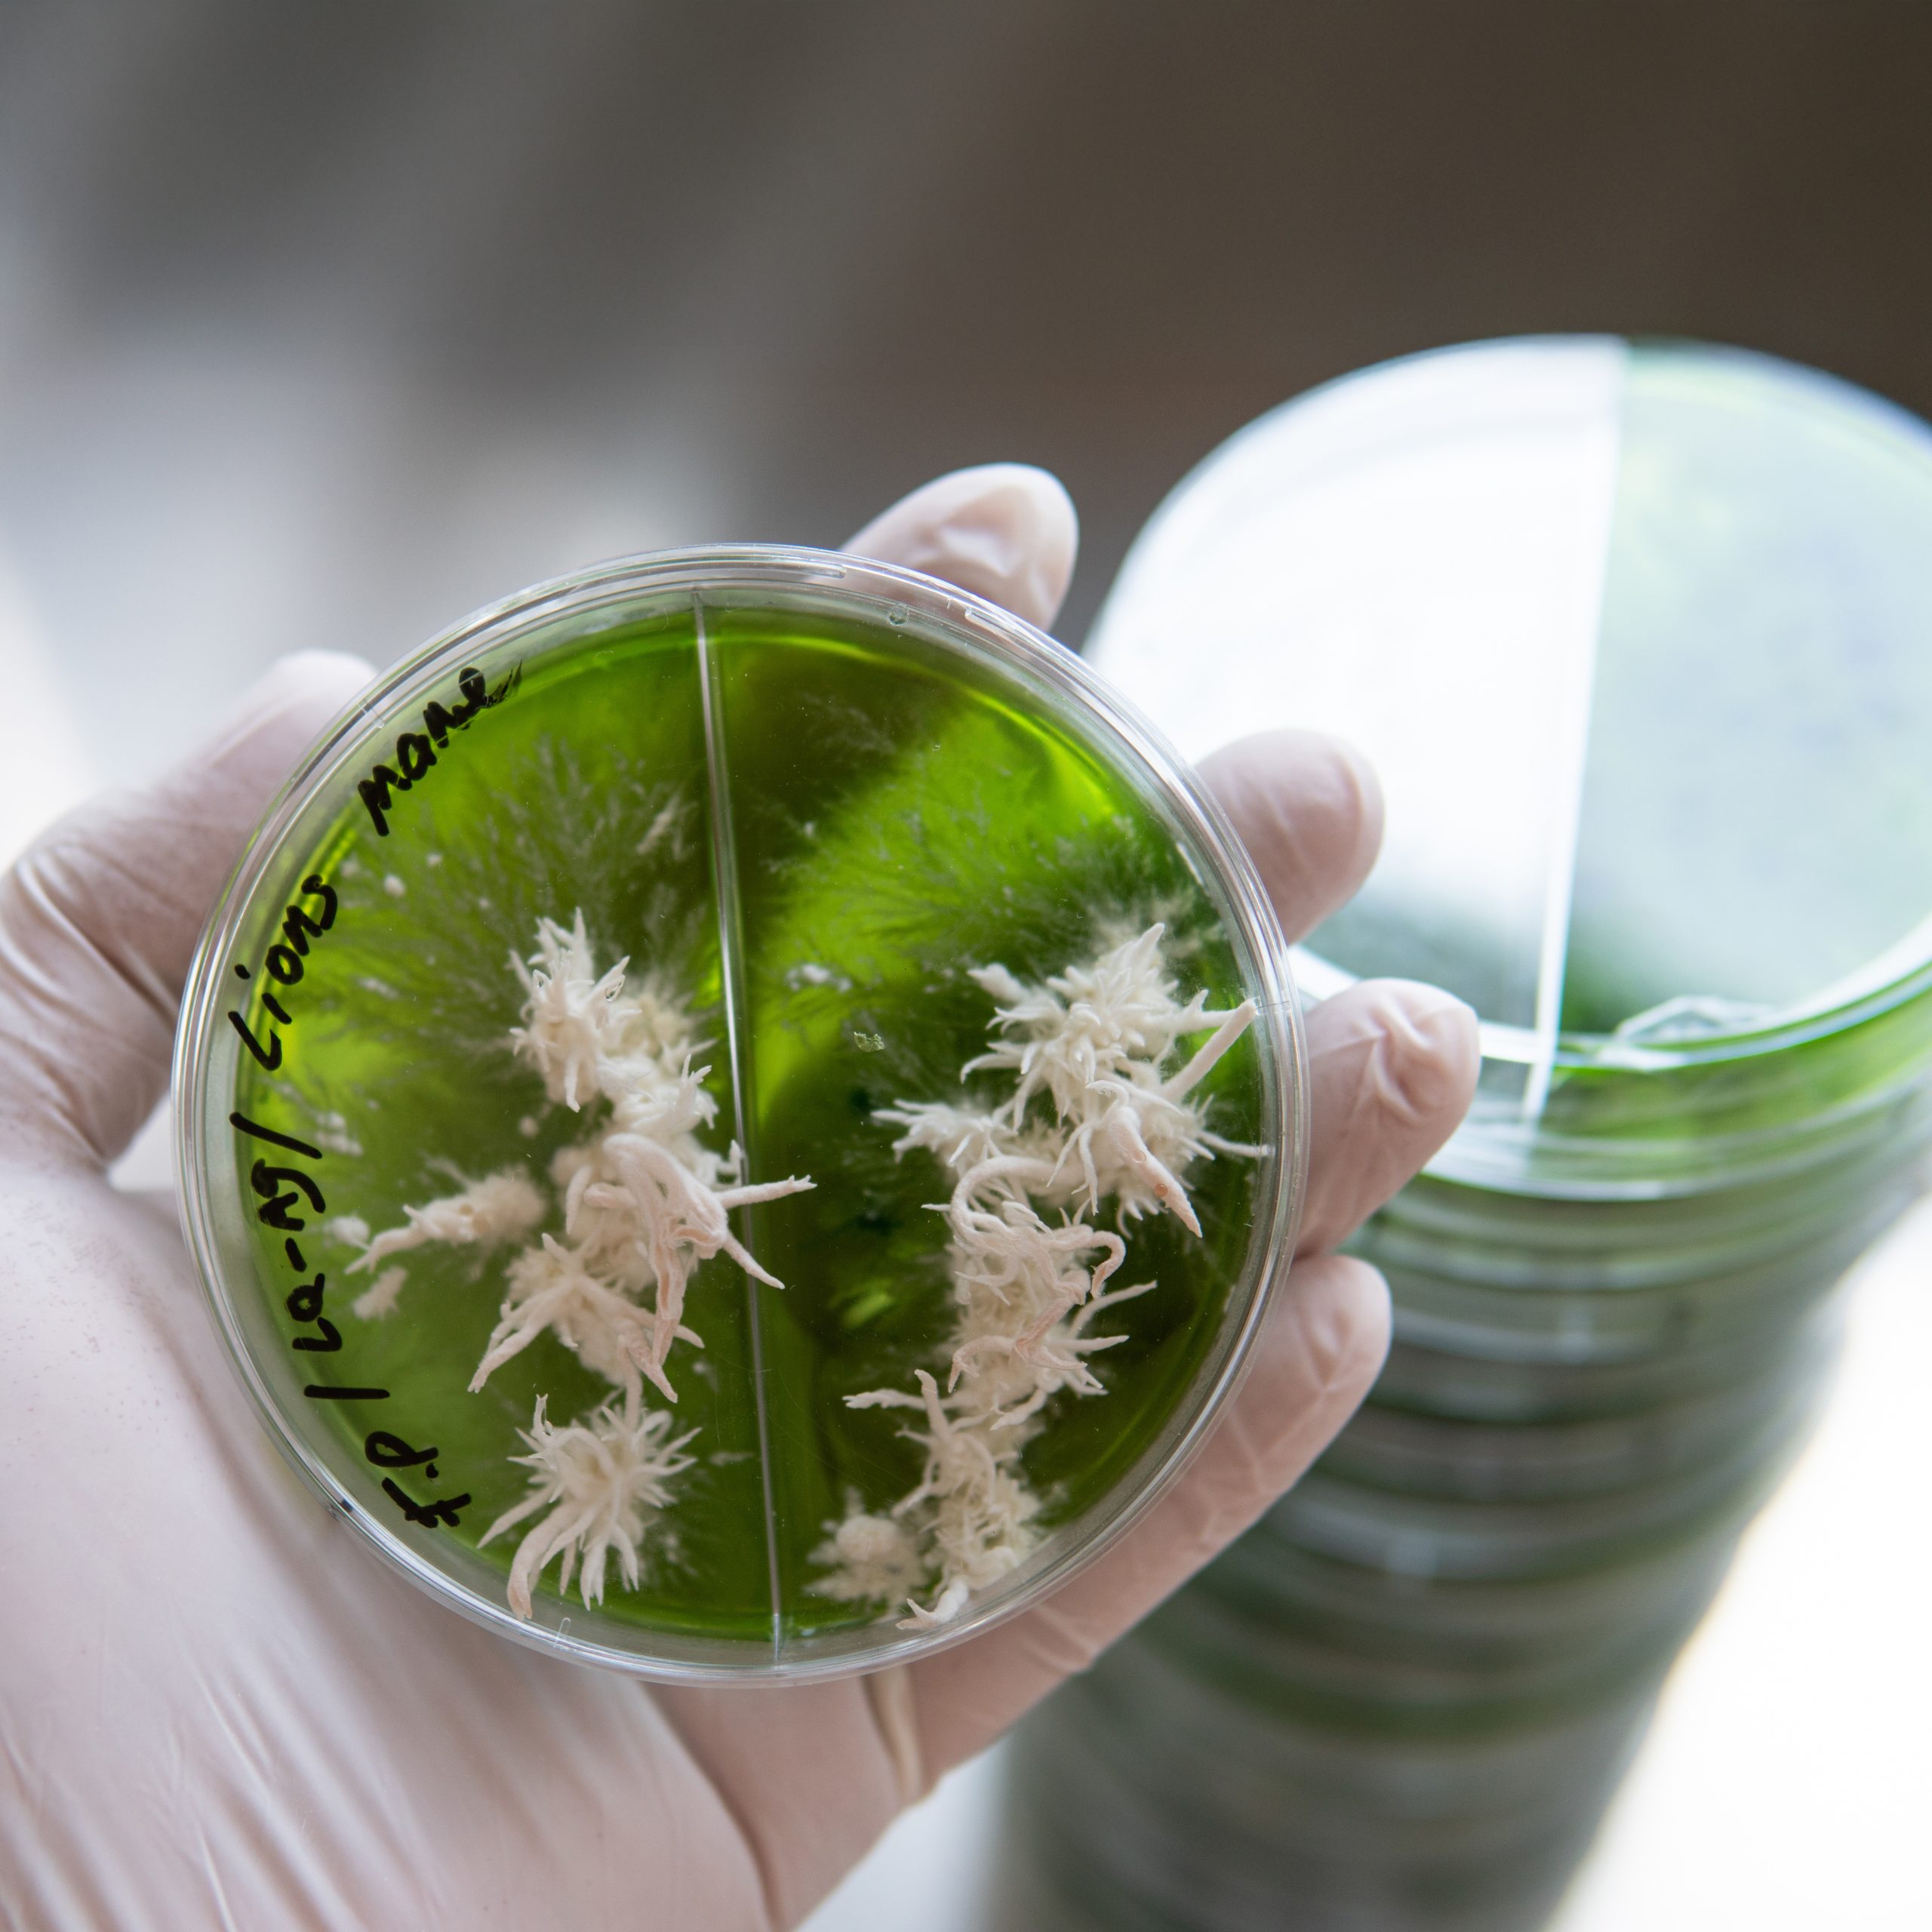
Mycology and conservation of mushroom cultures. Mycelium of the

Бестселлеры
Выберите категорию,
где нужна поддержка
О проекте FUNGILINE
FUNGILINE — лидер в разработке продуктов из грибов и растений
Компания основана Михаилом Вишневским, кандидатом биологических наук и ведущим российским микологом с более чем 30-летним опытом. Его исследования легли в основу создания инновационных решений для поддержки физического и эмоционального здоровья.
Мы объединяем научный подход с доказательной медициной, разрабатывая продукты, которые помогают сделать жизнь лучше. Мы не только изучаем грибы, но и делимся знаниями о них.

О проекте FUNGILINE
Цифры, которыми гордимся
прошедшее строгую
проверку качества.
грибах и растениях в
продуктах FUNGILINE
клиентов



О проекте FUNGILINE
Научная база FUNGILINE
- Разрабатываем продукты на основе исследований, опубликованных в ведущих научных изданиях
- Наша продукция сертифицирована, соответствует стандартам «Эко» и «Био», а также проходит регулярные лабораторные проверки
-
Все новинки тестируются
на фокус-группах
Отзывы

Ежовик Гребенчатый
Открытие этого года! Стал гораздо бодрее, и заметил огромный рост продуктивности, энергии и работоспособности. Категорически благодарен Михаилу и команде за качество!

Кордицепс
Либидо увеличилось (последний раз было такое в молодости), силовые показатели начали увеличиваться, спасибо за качественную продукцию.

Чага
Пью чагу уже несколько месяцев — укрепился иммунитет: никаких простуд, прошло вечное першение и боль в горле, улучшилось состояние кожи. Благодарю производителя.

Zen Micro
Мне этот курс подошел на все сто процентов. Состояние стало улучшаться уже на третий день. Сейчас — стабильно ровное и спокойное состояние, надеюсь, сохранится на длительное время.

Daily Men
Отличный продукт! Принимаю месяц и чувствую колоссальную разницу в общем состоянии тонуса и прилива физической и психологической силы!

Daily Women
Даже муж заметил изменения: кожа более упругая, тревожность уменьшилась, отеки ушли, критические дни меньше беспокоят, скинула 10 кг без спорта и диеты. Буду заказывать ещё

Снижение веса
Пью снижение веса пятый месяц. Вес уходит не быстро, а вот объемы стали уходить фактически после трех недель приема. С 85 кг., соскочила на 77 кг. (последний раз такой вес был лет 25 назад).

Психобиом
Были явные изменения в лучшую сторону, причем очень быстро. Нормализовался стул, ушли запоры, ушла бессонница, снизилась тревожность. Мигрени практически прекратились!

ЖКТ
Основное, что было мной замечено- это нормализация стула, при чем такая, какой у меня никогда ранее не было. Стабильно ходила в туалет утром и вечером. Это, как я считаю, сильный и весомый довод в пользу его приёма.
Частные вопросы от наши клиентов
Да, у нас есть доставка по миру. Вы можете ее оформить:
📦 На сайте fungiline.kz
Доставка возможна почти везде, кроме России, Австрии, Бельгии, Исландии, Испании и Нидерландов.
📦 На сайте fungiline.eu
Доставим во многие страны, кроме России.
📍 Или посетите наши магазины и филиалы
Мы собираем и отправляем заказы каждый день, кроме государственных праздников. Обычно передаем заказ в доставку в день оформления или на следующий. В период распродаж возможны задержки — спасибо за понимание.
Позвоните в наш контакт-центр:
Или обратитесь в поддержку через
WhatsApp: +7 (495) 149-99-97 или
Telegram: https://t.me/Fungi_Line
Сотрудники нашего офиса на связи с 10.00 до 19.00 по будням и с 10.00 до 17.00 — по выходным.
Самовывоз доступен во всех магазинах Москвы. Для получения заказа достаточно назвать его номер. Оплатить можно наличными или банковской картой.
Мобильное приложение FUNGILINE: https://fungiline.ru/app/
Мы представлены на крупных российских маркетплейсах. Ниже — ссылки на наши официальные магазины:
Ozon https://www.ozon.ru/brand/fungiline-100107235/
WB https://www.wildberries.ru/brands/fungiline
Полный ассортимент микродозингов можно найти на нашем сайте: myfungi.ru
Выбор зависит от ваших задач.
В FUNGILINE есть препараты и функциональные комплексы для укрепления здоровья и профилактики заболеваний. На страницах товаров найдете подробные описания действующих компонентов, рекомендации по приему и противопоказания.
А пока расскажем о самых популярных линейках и продуктах:
Для базовой поддержки организма
Подойдут комплексы линейки DAILY, а также универсальный продукт «Золотая капсула», который особенно полезен для взрослых и людей старшего возраста.
Для улучшения ментального состояния
Рекомендуем наш флагман RED MICRO или безмухоморный микродозинг ZEN MICRO.
Для концентрации и памяти
Комплексы «Ежовик гребенчатый» и «Ежовик гребенчатый+» помогут прокачать когнитивные функции.
Для решения конкретных задач
Обратите внимание на линейку COMPLEX — препараты, созданные для коррекции различных проблем со здоровьем.
Для ценителей растительной медицины
Линейка PHYTO объединяет препараты на основе экстрактов лекарственных растений восточной и аюрведической медицины.
Да, вы можете задать вопросы нашему фунготерапевту:
напишите на электронную почту фунготерапевта
(Вам ответят в течение 5 рабочих дней)
или получить индивидуальную платную консультацию
В составе — высококачественное сырье из дикорастущих и культивируемых грибов и лекарственных растений, прошедшее специальную обработку для усиления терапевтического эффекта.
Во-первых, грибные препараты обладают накопительным эффектом, поэтому их рекомендуется принимать курсами для достижения максимального результата.
Во-вторых, некоторые из них можно использовать на постоянной основе без риска снижения эффективности. К таким препаратам относятся ежовик гребенчатый, рейши, майтаке, и копринус.
Большинство наших препаратов можно сочетать для усиления терапевтического эффекта благодаря синергии грибов и растений.
Обычно один курс включает от 1 до 3 комплексов или 2–5 монопрепаратов.
Важно: мы не рекомендуем совмещать красный и пантерный мухоморы.
Практически все препараты нашей аптеки совместимы с лекарственными средствами, биодобавками и витаминами.
Для подробной информации о совместимости ознакомьтесь с разделами «Противопоказания» и «Особенности приема» в описании каждого препарата.































